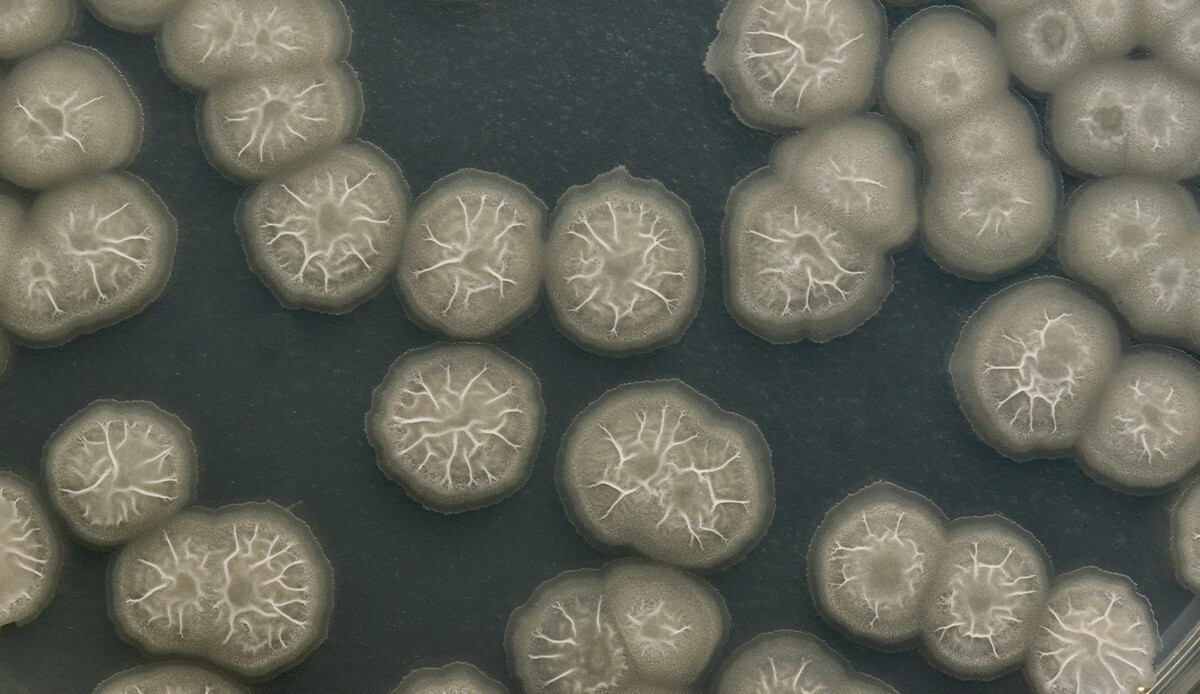
Musluk suyundan vücuduna girdi, ‘beyin yiyen amip’ nedeniyle hayatını kaybetti

Musluk suyundan vücuduna girdi, ‘beyin yiyen amip’ nedeniyle hayatını kaybetti
ABD’nin Florida eyaletinde bir kişi, nadir görülen beyin yiyen amip nedeniyle hayatını kaybetti. Sağlık yetkilileri, bu kişinin muhtemelen sinüslerini musluk suyuyla temizlerken amip kaptığını açıkladı.
Eyaletin güneybatısındaki Charlotta gerçekleşen olay büyük paniğe yol açtı. Florida Sağlık Departmanı’ndan yapılan açıklamaya göre enfeksiyon "musluk suyu kullanılarak yapılan sinüs durulama uygulamasından kaynaklandı.
Perşembe günü bakanlık enfekte kişinin öldüğünü doğruladı. Yetkililer konuyla ilgili araştırmanın devam ettiğini bildirdi.
SUYA NASIL BULAŞTIĞI İNCELENİYOR
Florida Sağlık Bakanlığı Basın Sekreteri Jae Williams, yaptığı açıklamada amibin suya nasıl bulaştığının incelendiğini açıkladı ve “Bu vakayla ilgili her türlü ek bilgi hasta mahremiyetini korumak için gizlidir” ifadelerine yer verdi.
Florida Sağlık Bakanlığı, bölge sakinlerini sinüs durulama işlemi esnasında yalnızca damıtılmış veya steril su kullanmaları konusunda uyardı. Musluk suyunun kullanılmadan önce kaynatılıp soğutulması gerektiğine dikkat çekildi.
BEYİN YİYEN AMİP NEDİR?
Naegleria fowleri adlı amip beyne burundan geçiyor. Beyinde enfeksiyona yol açan ve genellikle ölümcül olabilen, mikro ölçekli ve tek hücreli Naegleria fowleri burun yoluyla insan vücuduna giriyor.
Çoğunlukla göl, nehir, kanal gibi tatlı sularda bulunan amip, insandan insana geçmiyor. Naegleria fowleri enfeksiyonları, sıklıkla ABD'nin güney eyaletlerinde görülüyor.
Hastalığın belirtileri arasında baş ağrısı, ateş, baş dönmesi, kusma, yön duygusu kaybı, boyun ağrısı, denge kaybı, halüsinasyon ve nöbet yer alıyor.


















